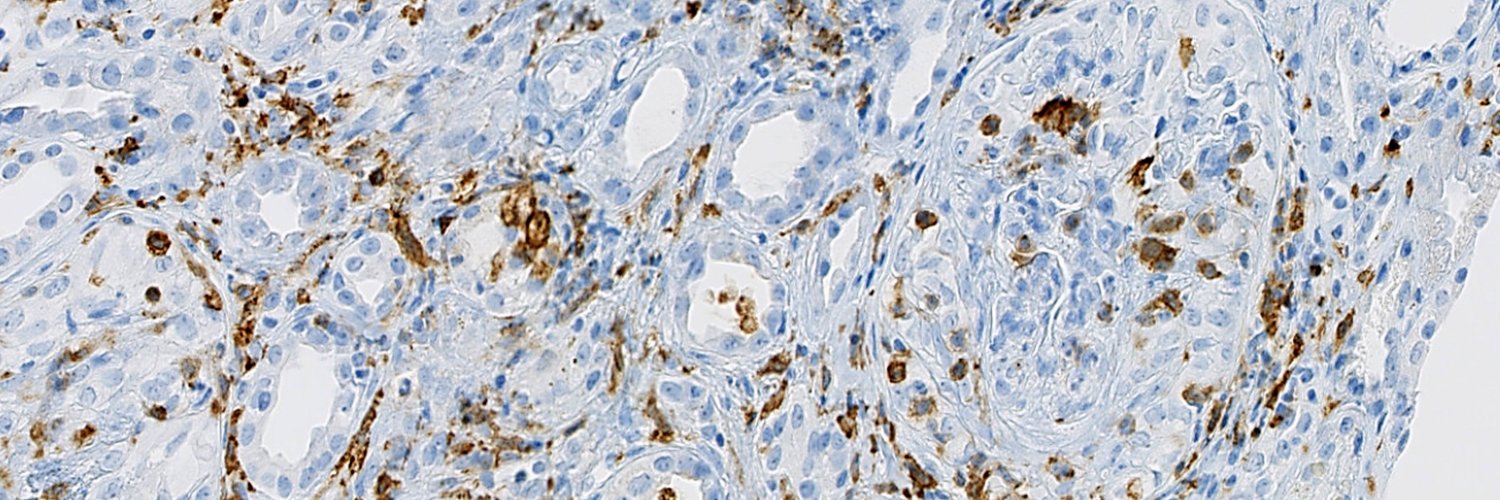
Trinity Kidneys banner

Trinity Kidneys
3.4K posts

Trinity Kidneys
@THKC1
Academic Nephrology unit in @tcddublin: focused on improving kidney health
Trinity Kidney Centre Katılım Eylül 2013
826 Takip Edilen1K Takipçiler


May is #LupusAwarenessMonth, a time to celebrate all #lupus champions and raise awareness about #lupus. We can’t do it alone, but together, #ManyOneCan!
Learn the many ways you can get involved with @LupusResearch by visiting bit.ly/ManyOneCan2025
English
Trinity Kidneys retweetledi
Trinity Kidneys retweetledi

ANCA-negative pauci-immune GN is reported to occur in up to 30% of cases; in Europe, it has a prevalence of 1-5% of cases. Our multi-centre series reported the largest cohort of 132 cases and was just published in @KIReports
kireports.org/article/S2468-…
Baseline char. are given!

English
Trinity Kidneys retweetledi

66% of #ANCA #vasculitis patients have coronary artery calcification (CAC score>0), indicating high cardiovascular risk, especially in MPO+. Only 25% are on statins. Urgent need for better screening and tailored cardiovascular prevention. @zach_wallace_md rmdopen.bmj.com/content/11/1/e…

English
Trinity Kidneys retweetledi

We are looking for a talented and motivated post-doc to work on new brain injury arising from systemic inflammation. Check it out here: universityvacancies.com/trinity-colleg… @hrbireland @tcdTBSI @tcddublin #delirium #neuroinflammation RTs appreciated !

English
Trinity Kidneys retweetledi

Exciting 1 year MSc by Research position is available in my lab, examining the novel roles of immune checkpoints in cancer cells. @CancerInstIRE @TCDTMI @TrinityMed1 @Irishimmunology @News_IACR @Researchirel

English
Trinity Kidneys retweetledi

3 more days to get your applications in the TTMI TY programme 2025 ⬇️
TTMI - Trinity Translational Medicine Institute@TCDTMI
🚨 The TTMI Transition Year Programme is open for applications 🚨 ➡️ Runs March 3 - 7th 2025 ➡️ Deadline for applications is Dec 20th 2024 ⬇️ Further details below
English
Trinity Kidneys retweetledi

The School of Medicine, Trinity College Dublin, is delighted to announce the publication of its Annual Overview of Doctoral Health Research 2024. Browse more than 100 Doctoral projects over the 12 days of Christmas tinyurl.com/55yppjb5

English
Trinity Kidneys retweetledi

RA post available in TTMI working with myself, Prof Mark Little and Dr Conor Finlay on pathological ANCA antibody-stimulated pro-inflammatory signalling in primary human monocytes and its inhibition. Please share with anyone you know who may be interested! my.corehr.com/pls/trrecruit/…
English
Trinity Kidneys retweetledi

🚨 PhD Opportunity! 🚨
Join our team to explore the fascinating link between immunity & coagulation in SLE! 🌟 Cutting-edge research, advanced training, & real-world impact await.
#PhD #Immunology #Thromboinflammation #Research



English
Trinity Kidneys retweetledi

We're recruiting for a number of key roles within the HSE's Technology and Transformation team. This is your chance to contribute to essential projects that directly support the future of healthcare in Ireland.
Check out the application forms and more information here➡️ pulse.ly/uwde9mdsmi
#Hiring #Career #HSE #Recruitment
@Jcwemyss @Frthompson @McCallionDamien

English

Seems to be exponential growth on B*sky - finally possible to ditch this cess pool?
bsky.app/profile/thkc.b…
English
Trinity Kidneys retweetledi

All the great and good are at the @eHealthIreland chief academic officer conference: “Academic Health Science Systems in a Digital Age”, an area that Ireland lags far behind in. Hopefully the link to the booklet not prescient

English
Trinity Kidneys retweetledi
Trinity Kidneys retweetledi

On our website, you can find testimonials from patients and family members living with a rare disease. If you would like to be a part of the PARADISE story as well, feel free to reach out to us through the form on our website:
🔗paradise-project.eu/public-and-pat…

English






